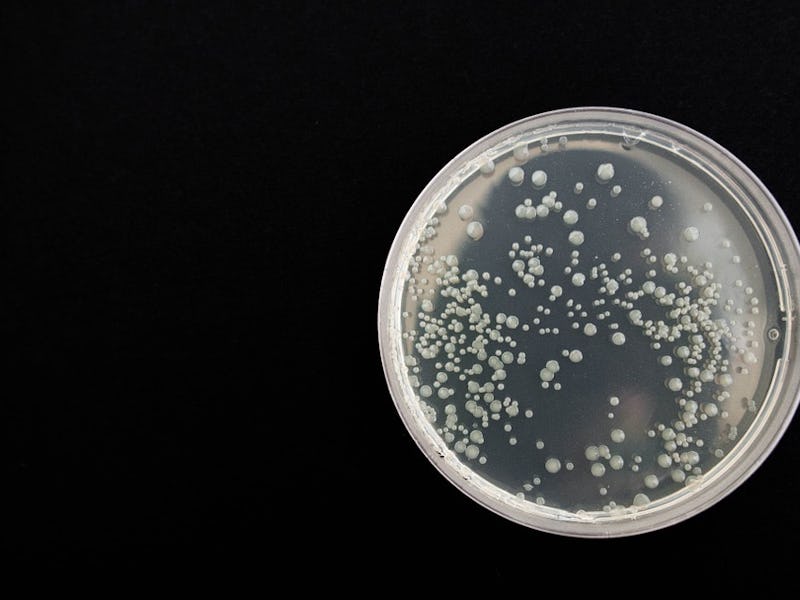

Scientists Identify a Bacteria That Grows Over Twice as Fast In Space Than on Earth
Space is the place for this particular organism.
Life on Earth evolved to live on Earth — so it’s no surprise to see that in most instances, organisms left to their own devices in space don’t exactly thrive. Even humans run into problems if we’re forced to spend long durations out in zero gravity environments.
So it’s a special thing to find that a particular bacteria researchers at the University of California, Davis sent to the International Space Station actually grows faster and better in space than it normally does here on Earth. The findings were published Tuesday in the journal PeerJ.
It’s all part of a national citizen science project called Project MERCCURI, in which the UC Davis team collected microbes from all around the country — from gyms and sports teams, to historical monuments, to schools and offices — and launched them up to the ISS to see how they would grow.
The winning bacteria? Bacillus safensis — a strain isolated from the NASA’s Mars Exploration Rover in 2004 — before the rover was launched. The bacteria managed to make its way to both California and Florida, and may have possibly been transported to Mars aboard the Opportunity or Spirit rovers.
It’s not exactly a huge shock to see that B. safensis can thrive in space. Bacillus microbes are notorious for their ability to withstand extreme environmental conditions. B. safensis itself is known to be resistant to salt, UV radiation, and gamma radiation.
Most of the bacteria samples aboard the ISS either grew the same or worse than they would have on Earth.
B. safensis managed to grow 60 percent better in space than Earth. And the research team has no idea why. They are currently sifting through the genome sequence of the microbe to see if there are any clues that point to why it exhibited such better growth in zero-gravity.
The implications for learning why are tremendous: If we’re able to isolate exactly what genes are responsible for the better growth, we could perhaps look for clues as to what kind of life might exist aboard worlds with different gravities. Furthermore, as human spaceflight begins to move toward Mars and beyond, it might be in our interest to learn how we can modify certain kinds of bacteria or plants that would prove useful for interstellar travel or colonization of other planets and moons.
As stated in a news release by David Coil, a microbiologist at UC Davis and the lead author of the study, ”Understanding how microbes behave in microgravity is critically important for planning long-term manned spaceflight — but also has the possibility of providing new insights into how these microbes behave in human constructed environments on Earth.”